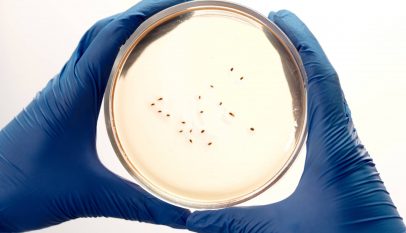
food dawn breakfast milk

Perhatikanlah berbagai hewan di sekitar kita! Kita akan mendapati hewan seperti nyamuk, kecoa, kupu-kupu, katak, burung, kucing dan lain-lain. Kita juga mungkin sering melihat jentik-jentik nyamuk, kecoa kecil, ulat, kecebong, anak burung dan anak kucing.
Dapatkah kamu membedakan bentuk muda dan dewasa dari hewan-hewan tersebut? Ya, sebagian hewan memiliki bentuk yang serupa ketika muda dengan dewasa, sebagian hewan lainnya memiliki bentuk muda yang sangat berbeda dengan ketika dewasa.
Pengertian Metamorfosis dan Metagenesis
A. Metamorfosis
Metamorfosis adalah suatu proses perkembangan biologi pada hewan yang melibatkan perubahan penampilan fisik dan/atau struktur setelah kelahiran atau penetasan. Perubahan fisik itu terjadi akibat pertumbuhan sel dan differensiasi sel yang secara radikal berbeda.
Beberapa serangga, amfibi, mollusca, crustacea, echinodermata, dan tunicata mengalami proses metamorfosis, yang biasanya (tapi tidak selalu) disertai perubahan habitat atau kelakuan.
Metmorfosis juga bisa diartikan sebagai perubahan bentuk yang terjadi pada makhluk hidup dari hewan muda sampai menjadi dewasa terjadi perubahan bentuk pada organ tubuhnya. Ciri utama makhluk hidup mengalami metamorfosis adalah bentuk tubuh pada saat muda akan berbeda ketika disaat dewasa, misalnya pada kupu-kupu, katak, belalang dll.
Pada masa muda kupu-kupu terbentuk dari ulat dan kemudian berubah jadi kepompong sampai ahirnya menjadi kupu-kupu. Metamorfosis dibedakan menjadi 2 jenis, yaitu metamorfosis sempurna dan metamorfosis tidak sempurna
1. Metamorfosis sempurna
Yaitu perubahan bentuk hewan melalui fase pupa atau kepompong misalnya kupu-kupu.
2. Metamorfosis tidak sempurna
Yaitu perubahan bentuk hewan tanpa melalui fase pupa, tetapi melalui fase nimfa (hewan muda), misalnya belalang dan kecoak.
Pada hewan bertulang belakang (vertebrata), metamorfosis terjadi padda katak. Secara umum, proses metamorfosis katak sebagai berikut.
- Katak betina dewasa mengeluarkan telur ke air. Selanjutnya telur tersebut dibuahi oleh spermazoa dari katak jantan dewasa. Pembuahan diluar tubuh seperti ini disebut pembuahan luar.
- Perkembangan telur berlangsung 12 hari.
- Berudu (fase larva) merupakan bentuk dari embrio. Berudu merupakan hewan muda yang bentuknya sama sekali berbeda dengan bentuk dewasanya.
- Pada berudu terbentuk kaki, insang luar, kemudian terbentuk pula insang dalam.
- Berudu berkaki kemudian berkembang menjadi katak muda yang berekor kecil, insang telah digantikan oleh paru-paru sebagai alat pernapasan.
- Berudu menjadi katak dewasa.
B. Metagenesis
Pada tumbuhan paku terjadi reproduksi vegetatif (fase sporofit) dan reproduksi generatif (fase gametofit) secara bergantian atau bergiliran. Proses itu disebut metagenesis. Spora merupakan alat reproduksi pada fase sporofit. Sebelum berbentuk spora, terjadi proses pembentukan gamet dan fertilisasi (fase gametofit).
Tumbuhan paku yang sering kamu lihat merupakan generasi sporofit. Tumbuhan paku pada fase sporofit berukuran lebih besar dan berumur lebih lama dibanding fase gametofit. Fase sporofit ini menghasilkan spora. Spora pada tumbuhan paku biasanya terletak dipermukaan daun.
Setelah spora masak dan jatuh pada tempat yang cocok, spora dapat berkecambah berbetuk protalium. Protalium inilah yang akan tumbuh menjadi gametofit. Gametofit setelah dewasa membentuk anteridium dan arkegonium.
Anteridium akan menghasilkan spermatozoa dan arkegonium menghasilkan ovum. Apabila terjadi pembuahan spermatozoa dan ovum maka dapat terbetuk sporofit muda. Terbentuknya sporofit muda ini menunjukkan mulai terjadi generasi sporofit kembali.
Daur hidup pada tumbuhan Paku
Selain tumbuhan paku, tumbuhan lumut juga mengalami metagenesis. Pada lumut,, generasi sporofit selalu bergantung pada generasi gametofit. Sporofit umumnya lebih kecil dan berumur lebih pendek dibanding gametofit.
Pada prinsifnya proses metagenesis merupkakan pergantian keturunan. Dalam satu siklus hidup terjadi pergantian keturunan antara individu penghasil spora dan individu penghasil gamet (sel kelamin). Individu yang menghasilkan spora berbeda dengan individu yang menghasilkan sperma.
Antara dua dua individu tersebut tidak pernah hidup bersamaan, tetapi masa hidup mereka bergantian atau bergiliran. Selain pada paku dan lumut., metagenesis juga terjadi pada hewan tingkat rendah atau Avertebrata. Misalnya cacing dan ubur-ubur.
Kesimpulan :
Metmorfosis adalah perubahan bentuk yang terjadi pada makhluk hidup dari hewan muda sampai menjadi dewasa terjadi perubahan bentuk pada organ tubuhnya.
Ciri utama makhluk hidup mengalami metamorfosis adalah bentuk tubuh pada saat muda akan berbeda ketika disaat dewasa, misalnya pada kupu-kupu. Pada masa muda kupu-kupu terbentuk dari ulat dan kemudian berubah jadi kepompong sampai ahirnya menjadi kupu-kupu.
Sedangkan Metagenesis adalah proses pergantian keturunan pada tumbuhan dari fase sporofit (vegetatif) ke fase gametofit (generatif) secara bergantian atau bergiliran.

Thanks sob ilmu IPAnya sangat bermanfaat ! 😀
izin nitip juga ya,
Download Aplikasi Dan Game Terbaru